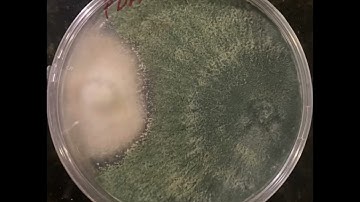
Timelapse Cultivos Duales (Trichoderma spp. y Fusarium spp.)

⬇ DOWNLOAD NOW
Kalau muncul iklan pop-up, tutup lalu klik tombol kembali
Download lagu Time-lapse Quality (Trichoderma asperellum) secara gratis hanya untuk keperluan promosi. Dukung artis favorit kamu dengan membeli musik original di iTunes atau platform resmi lainnya.
 Trichoderma Mold Fungi Timelapse
Trichoderma Mold Fungi Timelapse
 Trichoderma Viride Timelapse
Trichoderma Viride Timelapse
Timelapse Cultivos Duales (Trichoderma spp. y Fusarium spp.)
Timelapse Cultivos Duales (Trichoderma spp. y Fusarium spp.)
 Fungi Fighting Timelapse
Fungi Fighting Timelapse
 Monitoring ASPERELLO in practice
Monitoring ASPERELLO in practice
 Nematode en Trichoderma 240p
Nematode en Trichoderma 240p
 Timelapse Maxim FS480 Alternaria carrot new
Timelapse Maxim FS480 Alternaria carrot new
 Eutrema salsugineum time lapse stress and adaptation
Eutrema salsugineum time lapse stress and adaptation